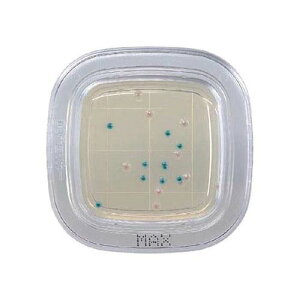
؂`FbN(R)DD MAXV|n 1 (20) PD0007

- pd (すべてのカテゴリ)
- DIY・工具
- 素材・補修材
- その他の素材・補修材
- 21ページ目
「pd」の人気商品一覧 | 安い商品を通販サイトから探す
20,908件 801〜840件を表示- 価格の安い順
- 価格の高い順
- 検索条件:
- その他の素材・補修材
- 本ページでは掲載するECサイトやメーカー等から購入実績などに基づいて手数料を受領しています。
その他の素材・補修材
●メーカー:Paloma(パロマ) ●型式:PD-72WS-75CV LPG(プロパン) ●種類:LPG(プロパン)

その他の素材・補修材
【特長】●プラスチック製ですから軽量で、持ち運びや施工の取り扱いがラクです。●ベージュ・カベ白・グレーの3色が取り揃えてあり、現場に合わせたカラーが選んでいただけます。●ワンタッチで取り付けられるはめ込み式の蓋は、取り付け取り外しが簡...

その他の素材・補修材
【特長】●プラスチック製ですから軽量で、持ち運びや施工の取り扱いがラクです。●ベージュ・カベ白・グレーの3色が取り揃えてあり、現場に合わせたカラーが選んでいただけます。●ワンタッチで取り付けられるはめ込み式の蓋は、取り付け取り外しが簡...

その他の素材・補修材
日東工器 03261 レバーロックカプラキャップ L-16PD ステンレス/ニトリルゴム プラグ用 流体機器 継手 低圧用
この商品で絞り込む

その他の素材・補修材
商品仕様の表面処理項目などを必ずご確認ください。 《仕様》 ●品種:(+)A六角PD=1(20X1 ●材質:鉄(または標準) ●表面処理:BC(黒クロメート)...
この商品で絞り込む

その他の素材・補修材
●メーカー:エスコ ●型式:EA618PD-100 ●梱包サイズ(mm):180×33×48 ●出荷目安:3営業日以内

その他の素材・補修材
[キーワード]未来工業 OF-11PD 感知器用はさみ枠 資材 電設資材 管工機材 工具 農業 耐震部材 工場 設備 通信 部品 パーツ 業務用 作業用 配線用 樹脂 鉄製 ボックス ケーブル 支持具...
この商品で絞り込む

その他の素材・補修材
特長 ●機種を豊富に取り揃え、あらゆる空気圧配管に対応します。 ●機種により取付け後、チューブの取出角度が変えられます。 ●条件により、水を流すことも可能です。

その他の素材・補修材
●色:ブラック●長さ(m):1.2

その他の素材・補修材
商品仕様の表面処理項目などを必ずご確認ください。 《仕様》 ●品種:4マークアプセットPD=3 ●材質:鉄(または標準) ●表面処理:クロメート...
この商品で絞り込む
その他の素材・補修材
●ぺたんと押して微生物チェックします。●特定の汚染菌の有無を選択的に確認できます。●一般細菌検出用培地は最短8時間で判定が可能です(発色液を使用)。●品名:MAX寒天培地●使用目的:大腸菌・大腸菌群同時検出用●測定する集落:
この商品で絞り込む

その他の素材・補修材
●メーカー:エスコ ●型式:EA824PD-1.8 ●梱包サイズ(mm):140×10×10 ●出荷目安:3営業日以内

その他の素材・補修材
●メーカー:日本ピスコ ●型式:PD4-01 ●出荷目安:3営業日以内

その他の素材・補修材
電設資材 ELPA 朝日電器 パーソナル配線器具 WLS-4322SUC-W 検索用カテゴリ425

その他の素材・補修材
【特長】●プラスチック製ですから軽量で、持ち運びや施工の取り扱いがラクです。●ベージュ・カベ白・グレーの3色が取り揃えてあり、現場に合わせたカラーが選んでいただけます。●ワンタッチで取り付けられるはめ込み式の蓋は、取り付け取り外しが簡...

その他の素材・補修材
広範な流体対応 高信頼性 優れた耐久性 簡単なメンテナンス ADK11シリーズ マルチレックスバルブ用部品

その他の素材・補修材
特長 ●機種を豊富に取り揃え、あらゆる空気圧配管に対応します。 ●機種により取付け後、チューブの取出角度が変えられます。 ●条件により、水を流すことも可能です。

その他の素材・補修材
在庫状況:お取り寄せ/取引先在庫あり3日〜5日で出荷/※使用可能な温度範囲は、使用条件によって異なります。※互換性:同じサイズであれば、プラグとソケットは取付形状にかかわらず接続できます。接続寸法がA-A-59326に準拠している製品...
この商品で絞り込む

その他の素材・補修材
●メーカー:エスコ ●型式:EA824PD-2.6 ●梱包サイズ(mm):170×10×10 ●出荷目安:3営業日以内

その他の素材・補修材
【メーカー特長】 ・小型化に成功したワンタッチ継手 ・スタンダードタイプに比べ容積比40%の小型化に成功 ・超小型でもチューブの脱着が簡単 ・解放リングは楕円形状を採用 φ1.8&φ2mmサイズ ・超細径チューブ配管用

その他の素材・補修材
特長 ●ライムチタニア系異種金属溶接棒です。 ●軟鋼とステンレス鋼の異種金属の溶接、クラッド鋼の溶接に適しています。 ●母材 鉄SS400、SUS304溶接可能です。 用途 ●異種金属の溶接に。 仕様<b
この商品で絞り込む

その他の素材・補修材
※事業者向け商品です※ メーカー エレコム 入数 1セット(5個入) 型番 MPA-CCF10PNFX5

その他の素材・補修材
【ご注意】・商品画像はサイズ違いや色違いを含む代表画像(イメージ)を使用している商品がございます。 ・モデルチェンジ等により仕様や色等の変更が生じる場合がございます。・画像の商品数と販売数は異なる場合がございます。(例:
この商品で絞り込む
この商品で絞り込む

その他の素材・補修材
【特長】●プラスチック製ですから軽量で、持ち運びや施工の取り扱いがラクです。●ベージュ・カベ白・グレーの3色が取り揃えてあり、現場に合わせたカラーが選んでいただけます。●ワンタッチで取り付けられるはめ込み式の蓋は、取り付け取り外しが簡...

その他の素材・補修材
【特長】●送り配管による感知器等の取り付けに使用します。●通常の送りエンドよりエンド内のスペースが大きくとれ、配線し易い形状です。●コネクタの取り付けによってL・T・X形に配管が可能です。●Gタイプだから管の接続解除も一発でOK!●ト...

その他の素材・補修材
【送料都度見積】●最高使用圧力(MPa):1.0●使用流体:空気、水●使用圧力:-100kPa●使用温度範囲(℃):0〜60(凍結なきこと)●形状:ブランチティー●色:開放リング:ライトブルー、樹脂本体:ライトグレー●適用ネジサイズ:...

その他の素材・補修材
】 品名:PISCO チューブフィッティング ブランチティー チューブサイズ4 適用ねじサイズR1/8 品番:PD4-01 適合チューブ外径D(mm):4×4 接続口径:R1/8 六角対辺(mm...

その他の素材・補修材
【メーカー特長】 ・あらゆる空気圧配管に対応 ・機種によりチューブの取出角度が自由に ・条件により水使用も可能 ・ソケットタイプがコンパクトに ・トリプルタイプとトリプルダブルタイプはコンパクトに集中配管が可能 【用途
![水本機械製作所 水本 ステンレス パッドアイ 35mm×120mm PD-12 [68-003297]](https://img1.kakaku.k-img.com/images/category/search/loading.gif)
その他の素材・補修材
※メーカー確認後の出荷となります!確認後欠品・廃番等の問題が発生しましたらご連絡いたします!ご了承願います ◆特長●設置幅の狭い面でも取り付け可能です。●座ぐりなしタイプです。●支柱や壁面等に取り付けます。◆用途◆仕様●使用荷重(kN...
この商品で絞り込む
![【在庫処分】アイリスオーヤマ プラダン 青 [断熱 遮音 ディスプレイボード 工作] PD-644](https://img1.kakaku.k-img.com/images/category/search/loading.gif)
その他の素材・補修材
●衝撃に強く、断熱効果や遮音効果に優れているプラスチックダンボールです●使用する用途によって選べる豊富な9色のカラーバリエーションです●移転・引越し時の建物への養生資材やディスプレイボード、工作材料等にご利用頂けます●また、通い箱や重...
この商品で絞り込む

その他の素材・補修材
防爆設計 高耐久ピストン駆動 差圧0作動可能 省エネルギー ADK21シリーズ マルチレックスバルブ用部品

その他の素材・補修材
【サイズ】 180 x 45 x 20 mm 【重量】 83 g 【入数】 1 【原産国】 日本 PD12RP...
この商品で絞り込む

その他の素材・補修材
●色:シルバー●ケーブル長(m):約0.2m●幅(mm):29●奥行(mm):131●高さ(mm):13●ポート数:USB Type-Cポート×1 ※充電専用USB Power Deliveryポート、USB Type-Cポート×2、...

その他の素材・補修材
曲面にフィットするように、Vの形にカットされています。 仕様 L1(mm):70 L2(mm):54 W(mm):17.5 H(mm):34 S(mm):9 d(mm):4.2 T(mm):4.5<b

その他の素材・補修材
【特長】●送り配管による感知器等の取り付けに使用します。●通常の送りエンドよりエンド内のスペースが大きくとれ、配線し易い形状です。●コネクタの取り付けによってL・T・X形に配管が可能です。●Gタイプだから管の接続解除も一発でOK!●ト...

その他の素材・補修材
【メーカー特長】 ・あらゆる空気圧配管に対応 ・機種によりチューブの取出角度が自由に ・条件により水使用も可能 ・ソケットタイプがコンパクトに ・トリプルタイプとトリプルダブルタイプはコンパクトに集中配管が可能 【用途

その他の素材・補修材
商品仕様の表面処理項目などを必ずご確認ください。 《仕様》 ●品種:(+)アプセットPD=3(W特寸 ●材質:鉄(または標準) ●表面処理:三価ホワイト...
この商品で絞り込む

その他の素材・補修材
電設資材 日東工業 PD形制御盤キャビネット PD20-A04 検索用カテゴリ1056

その他の素材・補修材
●色:ラベンダー●長さ(m):約1m●コネクタ形状:USB Type-C(TM)プラグ - USB Type-Cプラグ

その他の素材・補修材
【特長】●プラスチック製ですから軽量で、持ち運びや施工の取り扱いがラクです。●ベージュ・カベ白・グレーの3色が取り揃えてあり、現場に合わせたカラーが選んでいただけます。●ワンタッチで取り付けられるはめ込み式の蓋は、取り付け取り外しが簡...

その他の素材・補修材
【特長】●送り配管による感知器等の取り付けに使用します。●通常の送りエンドよりエンド内のスペースが大きくとれ、配線し易い形状です。●コネクタの取り付けによってL・T・X形に配管が可能です。●Gタイプだから管の接続解除も一発でOK!●ト...
その他の素材・補修材カテゴリで検索されているキーワード:
お探しの商品はみつかりましたか?
検索条件の変更
ご利用前にお読み下さい
- ※ ご購入の前には必ずショップで最新情報をご確認下さい
- ※ 「掲載情報のご利用にあたって」を必ずご確認ください
- ※ 掲載している価格やスペック・付属品・画像など全ての情報は、万全の保証をいたしかねます。あらかじめご了承ください。
- ※ 各ショップの価格や在庫状況は常に変動しています。購入を検討する場合は、最新の情報を必ずご確認下さい。
- ※ ご購入の前には必ずショップのWebサイトで価格・利用規定等をご確認下さい。
- ※ 掲載しているスペック情報は万全な保証をいたしかねます。実際に購入を検討する場合は、必ず各メーカーへご確認ください。
- ※ ご購入の前にネット通販の注意点をご一読ください。
- ※ 本ページでは掲載するECサイトやメーカー等から購入実績などに基づいて手数料を受領しています。
- pd
- DIY・工具
- 素材・補修材
- その他の素材・補修材の通販情報・価格比較
- 価格.com
© Kakaku.com, Inc. All Rights Reserved. 無断転載禁止



